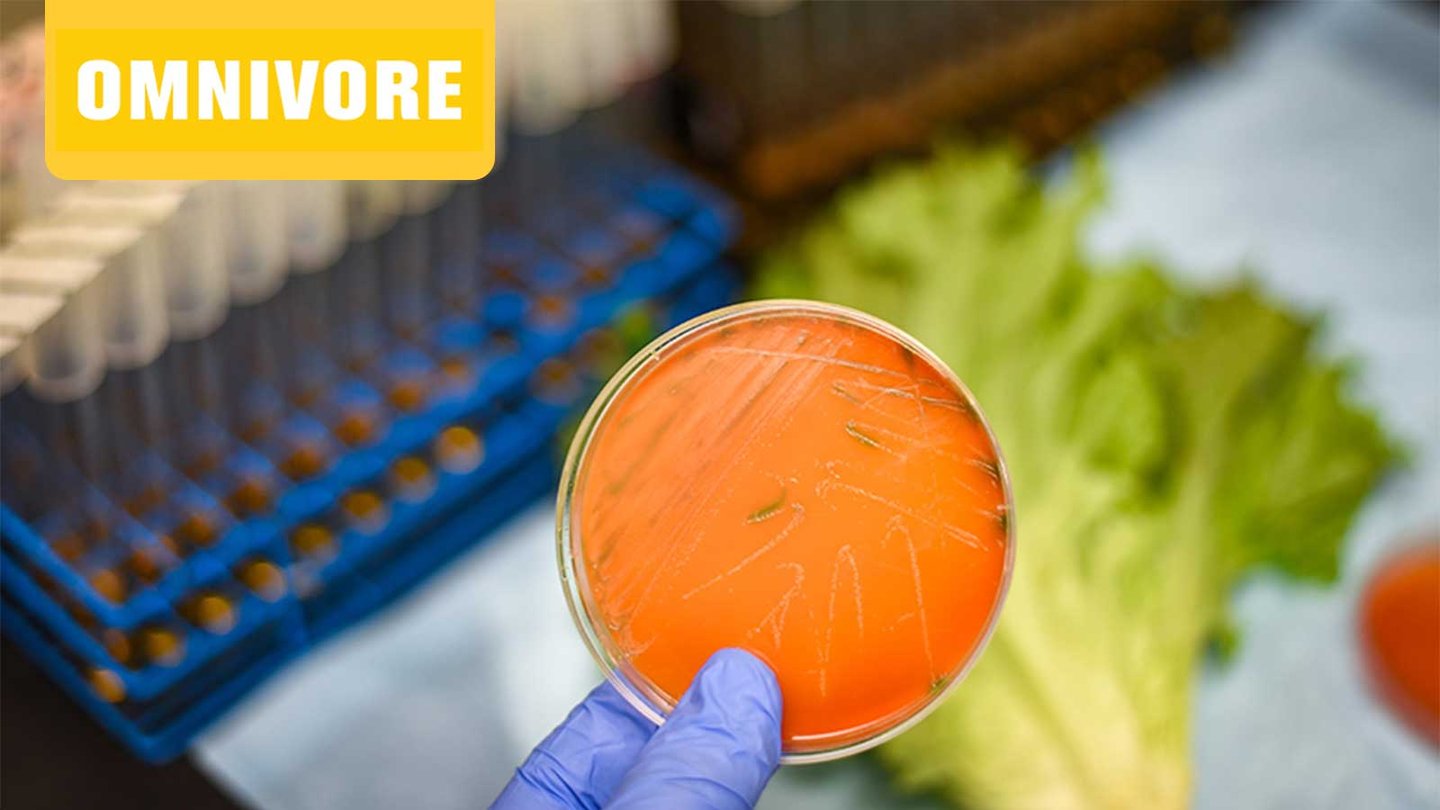
Omnivore EP 14 scientist holding a petri dish

Episode 14
The Art of Science Communication, Citrus Greening Disease, Organic Acid Redux
Episode Description
In the June episodes of Omnivore, Food Technology magazine’s award-winning editors bring you into the room with a not-to-be-missed line-up of food scientists and industry thought leaders.
Science communication expert Laura Lindenfeld explains how theatrical improv can help scientists break down barriers and better covey complex ideas. Researchers Anne Plotto and Matthew Mattia describe their efforts to overcome the impact of citrus greening disease by developing orange tree hybrids that produce fruit that is both delicious and disease resistant. While there are a lot of benefits organic acids bring to the product formulation and processing table, as microbiologist Erdogan Ceylan tells us, there are a few watchouts when applying these compounds to different food matrices.
Plus: Find out how Kalsec’s DuraShield Natural Food Protection Blends help extend shelf life while keeping your meat or poultry product's label clean.
Listen and subscribe on Apple Podcasts, Google Podcasts, Spotify, or wherever you listen to podcasts.

Featured Guests
-

Laura Lindenfeld PhD
Laura Lindenfeld, PhD, is executive director of the Alan Alda Center for Communicating Science and Dean of the School of Communication & Journalism at Stony Brook University. With co-author Fabio Parasecoli, she explores the intersection of food and popular culture in her book, “Feasting Our Eyes: Food Films and Cultural Identity in the United States.”
-

Anne Plotto
Anne Plotto, PhD, is a research plant physiologist with the U.S. Department of Agriculture’s Agricultural Research Service at the U.S. Horticultural Research Laboratory in Fort Pierce, Fla. Her current research focuses on flavor analysis and sensory evaluation of fruit and fruit products as affected by genotype, postharvest conditions, and processing. Currently, her main focus is evaluating flavor of citrus hybrids tolerant to the citrus greening disease.
-

Matthew Mattia
Matthew Mattia, PhD, is a research geneticist with the U.S. Department of Agriculture’s Agricultural Research Service at the U.S. Horticultural Research Laboratory in Fort Pierce, Fla. He is a plant breeder and horticulturalist who has started and led several breeding programs in a wide range of crop species. His current emphasis is breeding new citrus scion varieties.
-

Erdogan Ceylan
Erdogan Ceylan, PhD, is director-scientific affairs with Mérieux NutriSciences and chair of IFT’s Refrigerated and Frozen Foods Division. He is an award-winning food safety and quality executive with 25 years of experience in industrial research, food processing, operational food safety issues, troubleshooting, crisis management and regulatory affairs.
Categories
-
Food Categories
-
Organic
-
Podcasts
-
Omnivore
Omnivore
IFT’s Omnivore and Omnivore Presents: SciDish podcasts spark lively, thought-provoking conversations with the science, business, and regulatory leaders shaping the future of food. Each episode delivers sharp analysis, practical insights, and bold ideas designed to challenge assumptions, ignite innovation, and energize your work across the global food system.
Recent Podcasts

Mar 23, 2026
2026 Consumer Food Trends, Why Alt-Meat Is a Long Game
Dr. Liz Sloan shares her take on the defining consumer trends of 2026. And John Ruff draws on decades of product development experience to explain why alternative meat is a long game.
Podcasts

Mar 16, 2026
How Food Science is Reinventing Meat
Bruce Friedrich explores how cultivated and plant-based meat could reshape food production—and what it means for the future of protein.
Podcasts

Feb 23, 2026
Deconstructing America’s New Dietary Guidance, Unlocking Sustainable Fat Innovation
Nutrition experts break down the new U.S. Dietary Guidelines and explore how animal-free fats are improving taste and mouthfeel in plant-based foods.
Podcasts

